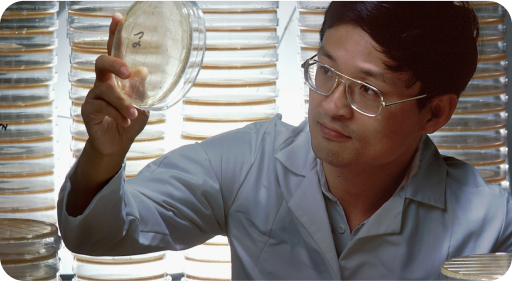
Scientist looking at a petri dish

Three steps to earn HAIR
Use your HAIR

Govern to Cure
HAIR holders have governance rights over our treasury, and are asked to decide what research we fund, and how our IP portfolio is managed
GOVERNANCE FORUM

Stake for Alpha
HAIR holders can use their tokens to receive confidential information, including early-access to our research data. Alpha enables HAIR holders to earn more HAIR.
STAKE YOUR HAIR

Purchase with Discounts
HAIR holders receive a 25% discount on all HairDAO products, including our patented treatments and trademarked software.
VISIT STORE
1,533,338
Total HAIR supply
658,448
HAIR in circulation
358
HAIR Holders
53,530
HAIR issued to community
HAIR distribution
1,533,338 HAIR
total supply
.png)
 HAIR Core (Unlocks 2026) | 20.5% |
 Fair Launch Auction | 10.7% |
 OTC Purchasers | 24.7% |
 Hair Cuts | 3.0% |
 Open Market | 4.6% |
 Strategic Partners | 1.0% |
 Unallocated | 35.5% |
* Unallocated HAIR is reserved for community members, future funders, or will burned. All HAIR supply is governed by HAIR hodlers.
Treasury
The value of our patents, trademarks, and infrastructure is not included in the treasury calculations Below.
.png)
$48,357,557.74
HAIR | 83.1% |
ETH | 10.8% |
Uniswap Liquidity Pool | 2.6% |
USDC | 2.6% |
Spend to date
$ 661,907.54
.png)
 Treatment Research & Development | 76.73% |
 Software Development | 10.87 |
 Legal & Regulatory Consulting | 7.05% |
 Content Creation & Marketing | 1.68% |
 Miscellaneous Operating Costs | 3.68% |
Become a HairDAO citizen scientist and earn HAIR as a reward
Anonymously log your treatment progress, help us advance hair loss research, and earn governance rights in the DAO.
A NOTE FROM OUR LEGAL TEAM
HAIR is a governance token, serving solely for decision-making within the DAO. It does not represent an investment or an opportunity for economic gain. Holders should not expect any form of financial return from purchasing this token. Its purpose is exclusively to enable participation in governance decisions, without any implied promise of financial profit.




